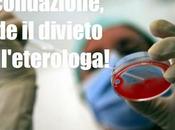
della Consulta alla fecondazione eterologa!

Freeskipper
 Descrizione
Descrizione
"freeskipper" il social network che fa opinione!
Più di ogni altra notizia quello che maggiormente ci sta a cuore è la tua opinione!
Tu scrivi i tuoi articoli, li spedisci via email a "[email protected]" e noi li pubblichiamo.
Benvenuto in team!
I MIEI BLOG
-
freeskipper
https://freeskipper.altervista.org/
il Social Network che fa opinione!
ULTIMI ARTICOLI (2870)
-
Farmaci che fino a ieri erano gratuiti, oggi si pagano!

Il Fondo monetario internazionale ci condanna dietro la Grecia in quanto a crescita e sviluppo. La disoccupazione è ai massimi storici. Leggere il seguito
Pubblicato il 14 aprile 2014 ATTUALITÀ, SOCIETÀ -
Statali: contratti bloccati fino al 2020, altro che "staffetta generazionale"!

Altro che prepensionamenti! Altro che svecchiamento della P.A. e staffetta generazionale! Qui a momenti non ci sono i soldi neppure per pagare gli stipendi degl... Leggere il seguito
Pubblicato il 11 aprile 2014 ATTUALITÀ, LAVORO, SOCIETÀ -
Fiat impacchetta le auto straniere dei dipendenti: Così mi spezzi il cuore!

Cosa non si fa per salvare il budget… "Così mi spezzi il cuore". Questo il messaggio forte e chiaro da parte dei vertici della Fiat indirizzato ai propri... Leggere il seguito
Pubblicato il 11 aprile 2014 ATTUALITÀ, SOCIETÀ -
We are One è l'inno ufficiale di Brasile 2014

''E' uscita, ragazzi! La canzone ufficiale dei Mondiali è disponibile adesso!'', ha scritto la cantante brasiliana Claudia Leitte sul suo profilo Instagram. Leggere il seguito
Pubblicato il 11 aprile 2014 MUSICA -
Magica Juve: bianconeri in semifinale di Europa League!

La Juve, stanca e poco brillante, inizia ad accusare l'accumulo di acido lattico nelle gambe, ma con la forza di chi è 'condannato a vincere' continua la sua... Leggere il seguito
Pubblicato il 11 aprile 2014 ATTUALITÀ, SOCIETÀ -
Prepensionamento Statali: i soldi non ci sono! Lo Stato lascia a casa i giovani...

Fumata nera, dopo l'approvazione del Documento di Economia e Finanza da parte del governo Renzi, circa la paventata "staffetta generazionale" che doveva attuars... Leggere il seguito
Pubblicato il 10 aprile 2014 ATTUALITÀ, SOCIETÀ -
Gran parte delle riforme di Renzi sono false, se non disastrose.

di Andrea Scanzi. Tutti vogliono il “cambiamento”, ma non tutti i cambiamenti sono positivi. Gran parte delle riforme di Renzi sono false quando non disastrose. Leggere il seguito
Pubblicato il 10 aprile 2014 ATTUALITÀ, SOCIETÀ -
Lombardia: Sì al referendum per abolire la legge Merlin.

Il Consiglio regionale lombardo ha approvato con 41 voti favorevoli (su 71 votanti) la proposta di indire un referendum abrogativo per la parziale abolizione... Leggere il seguito
Pubblicato il 10 aprile 2014 ATTUALITÀ, SOCIETÀ -
A te che voti Pd...

di Luigi Di Maio, M5S. A te che voti Pd: eleggi Pina Picierno al Parlamento italiano? E lei dopo un anno si candida al Parlameno Europeo, fregandosene del tuo... Leggere il seguito
Pubblicato il 10 aprile 2014 ATTUALITÀ, SOCIETÀ -
Alla faccia dei gufi, questa è l’Italia di Matteo Renzi.

Alle sei e mezzo del mattino, quando la maggior parte degli italiani è alle prese con la schiuma da barba, il latte, il caffè e le cartelle dei bambini da... Leggere il seguito
Pubblicato il 09 aprile 2014 MEDIA E COMUNICAZIONE, POLITICA, POLITICA ITALIA, SOCIETÀ -
Quegli 80euro in busta paga sanno tanto di... voto di scambio!

Gli 80euro in busta paga promessi dal governo per fine maggio a chi già percepisce stipendi da fame, hanno lo stesso sapore di quei 250.000euro incassati da... Leggere il seguito
Pubblicato il 09 aprile 2014 ATTUALITÀ, SOCIETÀ -
Sì della Consulta alla fecondazione eterologa!
La Corte Costituzionale ha dichiarato l'illegittimità della norma della legge 40 che vieta il ricorso ad un donatore esterno di ovuli o spermatozoi nei casi di... Leggere il seguito
Pubblicato il 09 aprile 2014 ATTUALITÀ, SOCIETÀ -
Il ddl della discordia.

Alleanze e maggioranze in politica vanno e vengono, e come fanno le bandiere sventolano dalla parte dove il vento soffia più opportuno e conveniente. Leggere il seguito
Pubblicato il 08 aprile 2014 ATTUALITÀ, SOCIETÀ -
Berlusconi: Forza Italia non si mangia la parola, barra dritta.

di Silvio Berlusconi. Come ho più volte ribadito, Forza Italia intende rispettare fino in fondo l’accordo stipulato con il Segretario del Pd, Matteo Renzi,... Leggere il seguito
Pubblicato il 08 aprile 2014 ATTUALITÀ, SOCIETÀ -
Doppio Llorente: la Juve spegne le speranze dei lupacchiotti!

'Re Leone' firma la doppietta che permette alla Juve di tornare a +8 dalla Roma. I giallorossi saranno pure più freschi e non distratti dall'Europa League, ma... Leggere il seguito
Pubblicato il 08 aprile 2014 ATTUALITÀ, SOCIETÀ -
Così Grillo le canta a 'Capitan Pizza'!

di Beppe Grillo. Il MoVimento5Stelle è ecumenico, è aperto a tutti i cittadini italiani che vogliano farne parte e disposti ad accettarne le poche, chiare e... Leggere il seguito
Pubblicato il 08 aprile 2014 ATTUALITÀ, SOCIETÀ -
Renzi, l'antivirus che bonificherà il 'Sistema-Italia' dai 5stelle?

Per poter esprimere un parere sul governo Renzi è ancora troppo presto. L’unica cosa che possiamo dire in merito al curriculum politico del Presidente del... Leggere il seguito
Pubblicato il 07 aprile 2014 ATTUALITÀ, SOCIETÀ -
Non si chiameranno più Province, ma Città Metropolitane!

"Quando mi recherò alla Provincia di Roma, busserò al portone e nessuno mi aprirà, solo allora crederò che hanno per davvero abolito le province."! Leggere il seguito
Pubblicato il 04 aprile 2014 ATTUALITÀ, SOCIETÀ -
Ergastolo è pena certa.

di Vincenzo Andraous. Accade sempre in ogni epoca di crisi e di trapasso; chi sta al fondo del barile, all’ultima fila di sedie, inchiodato alla propria... Leggere il seguito
Pubblicato il 04 aprile 2014 ATTUALITÀ, SOCIETÀ -
La Juve soffre, ma passa a Lione.

Fa bene la Roma a sperare e a continuare a crederci nella rimonta. La Juve, ieri sera a Lione vestita di giallo, è apparsa apatica e svogliata: appagata. Leggere il seguito
Pubblicato il 04 aprile 2014 CALCIO, SPORT
